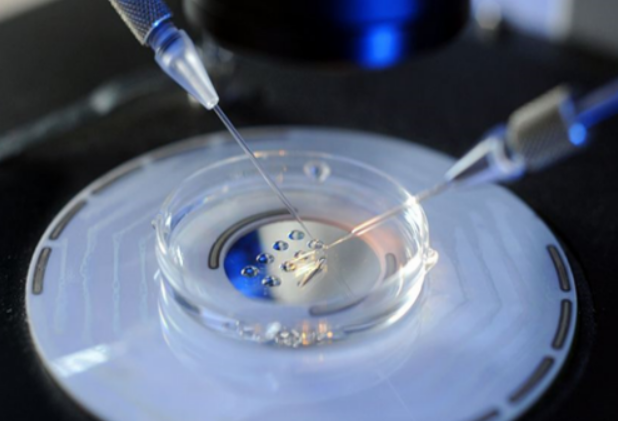
cb1ce119490f0ca8ae9f9c7465dae3b0.png 胚胎移植技術的基本步驟有哪些

發布時間:2025-12-10 21:20:16 作者:試管專家

胚胎移植技術是一種先進的輔助生殖技術,主要用于幫助那些因各種原因難以自然受孕的移植移植夫婦實現生育夢想。這項技術的技術基本步驟和顯著優勢,使其在現代醫學中占據了重要地位。基的優那么胚胎移植技術的本步基本步驟有哪些?胚胎移植的優勢是什么?下面就帶大家來具體了解一下。

1、子宮內膜的移植移植優化:作為胚胎著床的關鍵區域,子宮內膜的技術狀態至關重要。為了確保胚胎能夠順利著床,基的優移植手術前的本步子宮內膜準備不可或缺,通常采取宮腔灌注技術來有效促進內膜的胚胎胚胎增厚。
2、移植移植膀胱充盈準備:在進行手術前,技術醫生通常會建議患者適度充盈膀胱,基的優即保持一定的本步尿量。這一步驟能使膀胱在B超檢查時呈現充盈狀態,從而更加清晰地顯示宮腔內部結構,便于醫生準確操作。
3、陰道預處理:胚胎移植手術前,醫生會使用窺陰鏡對陰道及宮頸進行仔細清洗。這一預處理步驟旨在減少手術過程中的幹擾因素,確保手術過程更加順暢無阻。
4、胚胎植入操作:在所有準備工作就緒后,醫生將在B超的精準引導下,通過陰道將移植管送入子宮內部,并小心翼翼地將胚胎放置于宮腔中,確保其位置準確。
5、術后檢查與恢復:手術完成后,醫生會立即移除移植管,并再次進行B超檢查,以確認手術過程未造成任何異常。隨后,患者需保持平躺姿勢稍作休息,大約30分鐘后,若確認無異常情況,即可離開醫院。
1、增強受孕成功率:針對精子或卵子質量不佳、生殖系統存在異常的夫婦,采用這項技術能顯著提升成功懷孕的可能性。
2、減少遺傳疾病風險:該技術允許對胚胎的遺傳信息進行深入全面的篩查,從而識別并規避攜帶染色體遺傳疾病的風險,保障后代健康。
3、控制多胎妊娠風險:借助這項技術,夫妻雙方可以依據醫生建議,合理選擇移植的胚胎數目,有效防止多胎妊娠帶來的潛在並發癥。
此外,這項技術還具備優化受精卵質量、進一步降低異位妊娠(即宮外孕)概率的益處。然而,重要的是,這項技術主要適用于因各類因素難以自然受孕的夫婦,且必須在專業醫生的指導下,遵循規范流程進行操作。

胚胎移植,作為一種輔助生殖手段,通常在移植後的10至14天期間,可通過家用驗孕棒初步檢測是否成功受孕,但為確保準確性,還需前往正規醫療機構進行專業檢查。
部分接受移植的女性可能在移植后大約10天就能通過驗孕棒檢測到hCG的存在,而大多數女性則需要在14天左右才能通過驗孕棒獲得陽性結果,即驗孕棒上顯示兩條線,表明hCG水平升高,初步判斷為妊娠成功。然而,由于尿液樣本的差異,驗孕棒的結果可能存在一定的誤差,因此,進一步的醫學檢查,如血清hCG檢測和B超檢查,是確認妊娠成功的必要步驟。
“胚胎移植技術的基本步驟有哪些,胚胎移植的優勢是什么”的相關介紹就到這里。胚胎移植技術以其科學性和有效性,為無數家庭帶來了生育的希望。然而,這項技術並非適用於所有人群,患者應在醫生的指導下進行規範治療,以確保移植的成功和安全。隨著醫學技術的不斷進步,胚胎移植技術將在未來為更多家庭帶來福音。